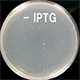
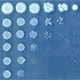

研究成果(プレスリリース)2016

2016年12月26日
タンパク質中の原子の動き、自由電子レーザーにより動画撮影に成功
2016年12月26日
ゲノム編集の落とし穴
2016年12月26日
代謝シミュレーションを簡便に行うツールを開発
2016年12月23日
体の一日を刻むタイマー機構を発見
2016年12月21日
真核微細藻類ユーグレナを使った「バイオコハク酸」の生産に成功
2016年12月20日
細胞死を司るカルシウム動態の制御機構を解明
2016年12月15日
シリコン基板上に窒化アルミニウム高品質結晶を製膜
2016年12月15日
アトピー性皮膚炎の発症・悪化・予防に関わる二重スイッチ
2016年12月14日
植物の青色光特異的伸長化合物を同定
2016年12月14日
新粒子候補テトラクォークZc(3900)の正体
2016年12月12日
世界最小の人工バネでタンパク質の動きを捉える
2016年12月12日
フェムト秒X線光電子回折法により強レーザー電場中の分子の構造を決定
2016年12月7日
転写分子の渋滞を発見
2016年12月7日
ネットワーク内部の情報の統合を定量化
2016年12月5日
原子の集団が数珠つなぎに電子を放出する
2016年12月2日
式が書ければ「京」が使える
2016年12月2日
T細胞の運命を制御する分子機構を解明
2016年12月2日
インフラの長寿命化を支える先進レーザー診断技術の開発
2016年11月30日
児童期の言語機能に遺伝要因が年齢に応じて関与
2016年11月28日
糖鎖は不均一であることが重要
2016年11月25日
電子2個のスピン情報の多値読み出しに成功
2016年11月25日
植物は侵入してきた病原体を兵糧攻めにして撃退する
2016年11月24日
再発性と多発性肝臓がんのゲノム診断
2016年11月22日
SARSウイルスの巧みな戦略
2016年11月18日
一遺伝子変異の遺伝的リスクと父の加齢との関係性を説明
2016年11月17日
高温で働く植物の遺伝子スイッチがデザイン可能に
2016年11月17日
生体内ゲノム編集の新技術を開発
2016年11月15日
休眠と冬眠の代謝制御機構の共通点を明らかに
2016年11月15日
小児慢性疲労症候群は報酬の感受性低下を伴う
2016年11月15日
過剰な恐怖を抑制するための脳内ブレーキメカニズムを解明
2016年11月14日
極性構造歪みの制御を通じた熱電変換効率の向上に成功
2016年11月11日
加齢黄斑変性発症に関わる新たな遺伝子型を発見
2016年11月10日
病原菌が鉄を細胞内に取り込む仕組み
2016年11月8日
有機両極性半導体による回路の低消費電力化に成功
2016年11月8日
ドーパミン受容体の機能に新視点
2016年11月4日
がんゲノムビッグデータから喫煙による遺伝子異常を同定
2016年11月4日
分子軌道性バンド絶縁体と相対論的モット絶縁体
2016年11月3日
睡眠・覚醒制御の分子ネットワーク解明への道を拓く新規遺伝子の発見
2016年11月2日
材料組織の画像解析クラウドシステムを開発
2016年11月2日
系外惑星の巨大リングの回転は公転と逆向き
2016年11月2日
SWEETタンパク質は植物ホルモン「ジベレリン」を輸送
2016年11月2日
患者由来iPS細胞による脊髄小脳変性症の病態再現
2016年11月2日
iPS細胞からみえる統合失調症の特徴
2016年11月1日
バクテリア細胞質の全原子分子動力学計算
2016年11月1日
中性子によるコンクリート内損傷の透視
2016年11月1日
ウイルスワクチンの新戦術
2016年10月28日
B型肝炎ウイルスの詳細な転写マップを作成
2016年10月28日
タンパク質合成を促進する「ジャンク」と呼ばれていたRNA
2016年10月27日
膜タンパク質の構造を迅速に解明する手法を開発!
2016年10月27日
1分子の構造変化による細胞集団運動の制御
2016年10月26日
尿や血中での有機反応で酸化ストレスを簡便に検出
2016年10月24日
生薬「甘草」のゲノム解読に成功
2016年10月21日
植物の青色光応答の初期過程を解明
2016年10月18日
嬉しい体験と嫌な体験は互いに抑制し合う
2016年10月17日
筋ジストロフィー症の原因となる糖鎖構造を解明
2016年10月17日
慢性疲労症候群の客観的診断に有効なバイオマーカーを発見
2016年10月17日
ミミズの筋肉を搭載した小型ポンプを開発
2016年10月14日
亜鉛が腸粘膜の増殖を制御する分子機構の一端を解明
2016年10月14日
新手法「暗視野X線タイコグラフィ」の実証に成功
2016年10月13日
水中・室温・無触媒で起こるアミド化反応
2016年10月13日
染色体の形と分離の関係
2016年10月13日
横滑りX線導波管
2016年10月11日
簡単手順で長期安定的な細胞の区画培養
2016年10月11日
植物の細胞壁を改変
2016年10月4日
分子間エネルギー移動の単分子レベル計測に成功
2016年10月1日
医薬品骨格に多く見られる炭素−窒素結合の新しい分子変換法を開発
2016年10月1日
細胞内のカルシウム濃度を一定に保つメカニズムを解明
2016年9月30日
イオン用超伝導加速空洞の高加速電圧試験に成功
2016年9月30日
他人を記憶するための海馬の仕組み
2016年9月27日
低速多価イオンビームの太さを髪の毛の1/100に
2016年9月26日
宇宙空間の分子が放つ新しい発光現象
2016年9月26日
新規セスキテルペン生合成遺伝子の発見
2016年9月20日
離れた細胞間の物質輸送やシグナル伝達を担う脂質膜ナノチューブの形成を誘導する仕組み
2016年9月20日
水素分子の解離過程を8フェムト秒で制御
2016年9月20日
マウスで難病遺伝子を探索
2016年9月20日
マウスの大規模解析データを世界へ
2016年9月20日
室温スキルミオン格子の構造転移
2016年9月17日
植物青色光受容タンパク質の形と光受容変化
2016年9月16日
iPS細胞由来網膜細胞の免疫拒絶反応モデルの開発
2016年9月16日
スピン軌道相互作用による磁壁のトラップ
2016年9月15日
走査型蛍光X線顕微鏡を用いた細胞内脂質イメージング
2016年9月13日
窒素分子から直接ニトリルを合成
2016年9月13日
胎生動物出現の鍵:糖による新たなエピジェネティック修飾を発見
2016年9月2日
日本食の抗疲労効果を科学的に立証!成果を「抗疲労レシピ本」に
2016年9月2日
ゴルジ体槽成熟の分子機構を解明
2016年9月2日
Sar1の生細胞内三次元局在を可視化
2016年9月1日
電場によるスキルミオンの生成・消滅に成功
2016年9月1日
生体親和性の高いバイオプラスチック
2016年9月1日
環境の変化によって自在に色を変える水
2016年8月31日
ポリマー末端基の新測定法
2016年8月31日
ワンポット合成で天然物を神経分化調節分子へ
2016年8月30日
神経新生の生体イメージングに成功
2016年8月26日
大腸がん幹細胞を抑制する新規化合物を創出
2016年8月25日
生体分子の電荷分布の高精度解析法
2016年8月23日
紫外線から植物を守る
2016年8月22日
マイタケ由来タンパク質がインフルエンザウイルスの増殖を抑制
2016年8月22日
天然シリコンにおける高性能量子ビット実装
2016年8月18日
高分子量バイオプラスチックを生産する海洋性の光合成細菌
2016年8月18日
ヒトiPS-NKT細胞の抗腫瘍効果を生体内で示すことに成功
2016年8月16日
超高精度の「光格子時計」で標高差の測定に成功
2016年8月11日
硫化水素の新たな結晶構造「マグネリ相」を発見
2016年8月9日
免疫を司るHLA遺伝子など6遺伝子領域が関与
2016年8月9日
「京」と最新鋭気象レーダを生かしたゲリラ豪雨予測
2016年8月8日
「達成感」による脳内変化を明らかに
2016年8月5日
両極性動作する有機モット転移トランジスタを実現
2016年8月5日
継続的更新に対応する細胞-遺伝子活性データベース
2016年8月5日
非古典的HLA遺伝子の関節リウマチ発症への関与が明らかに
2016年8月1日
タンパク質の二次構造を決定する新たな手法を開発
2016年8月1日
細胞を使わない膜タンパク質の合成技術
2016年7月26日
毒のないジャガイモ
2016年7月26日
トポロジカル絶縁体表面で高効率スピン流を生成
2016年7月25日
マイクロ波単一光子の高効率検出を実現
2016年7月22日
糖鎖の高感度検出に成功
2016年7月22日
分子モーターの「バックギア」を解明
2016年7月21日
化学反応ネットワークの新原理「限局則」を発見
2016年7月20日
光照射だけでスピン偏極電流が発生する磁性トポロジカル絶縁体
2016年7月20日
トポロジカル絶縁体の量子化磁気光学効果の観測
2016年7月20日
火星ダストデビルの性質を解明
2016年7月20日
水素を合成する遺伝子の改変でバイオプラスチック原料の増産に成功
2016年7月19日
環境の変化を感知し、半永久的に駆動するアクチュエーター
2016年7月15日
躍動する光合成反応を可視化
2016年7月14日
光合成のメカニズム解明に一歩前進
2016年7月13日
スーパーコンピュータ「京」が Graph500で世界第1位を獲得
2016年7月11日
細胞を活性化できるチタン
2016年7月9日
酸化物界面を用いたスキルミオン制御
2016年7月7日
寄生植物の侵入器官発生メカニズムの一端を解明
2016年7月6日
加齢に伴うグリコーゲンの脳内分布変化を可視化
2016年7月1日
がん免疫の課題を克服する治療モデルを構築
2016年7月1日
後縦靭帯骨化症の発症に関わる遺伝子RSPO2を発見
2016年6月29日
並列計算で感覚情報を分解
2016年6月28日
脂質分解酵素が細胞膜をチューブ状に変形
2016年6月27日
免疫を活性化させるミクロシナプス構造を発見
2016年6月24日
植物アルカロイドの生産性はアミノ酸代謝酵素の収斂分子進化に起因することを明らかに
2016年6月24日
天然ゴムのドラフトゲノムを解読
2016年6月21日
ニホンウナギの光るたんぱく質UnaGによるビリルビン測定
2016年6月20日
アルマ望遠鏡で見えてきた化学組成の多様性
2016年6月20日
ガラス湾曲を利用した微粒子分離
2016年6月17日
半炭化バイオマスを用いた土壌改良の包括的評価法
2016年6月17日
X線自由電子レーザーの超短パルスでリボ核酸塩基分子中の電荷と原子の動きを可視化!
2016年6月17日
匂いの好き嫌いを決める脳内メカニズムを解明
2016年6月14日
止血役にはストレスが必要
2016年6月14日
磁性体に内在しているスピン流の役割を解明
2016年6月10日
水表面の電子を観測
2016年6月9日
シルクの材料特性とアミノ酸配列の相関を解明

2016年6月7日
テラヘルツ光照射による高次構造変化を実現
2016年6月7日
微細加工した絶縁体表面で電子の蓄積の観察に成功
2016年6月3日
電子1個のスピン情報の長距離伝送・検出に初めて成功
2016年6月2日
正確な場所情報には海馬CA3からの入力が重要
2016年6月2日
ペルフルオロアルキル化合物の実用的な合成法
2016年6月1日
スピンをレーザーで制御する
2016年6月1日
アミロイドペプチドの凝集を阻害する生体反応を発見
2016年5月31日
シビレエイ発電機
2016年5月31日
新規タンパク質定量法「MS-QBiC」による体内時刻の測定
2016年5月31日
魚の求愛行動を促進するフェロモン受容体の発見
2016年5月27日
スピン液体近くの”隠れた秩序”
2016年5月27日
植物の環境応答を向上させるゲノム編集技術の確立
2016年5月27日
高温超伝導体の2つの顔
2016年5月27日
遷移金属酸化物で量子ホール効果を実現
2016年5月27日
睡眠不足でも脳への刺激で記憶力がアップ
2016年5月26日
フレキシブルな世界最薄のガラス流体チップを開発
2016年5月25日
北極域への「すす」の輸送メカニズムを解明
2016年5月24日
双極性障害(躁うつ病)にデノボ点変異が関与
2016年5月24日
油を多く産生するユーグレナ変異体を選抜する品種改良法の開発に成功
2016年5月24日
「2度あることは3度あるか?」を脳が計算
2016年5月20日
機能性ポリマーの新しい合成法を開発
2016年5月18日
X線自由電子レーザーによる非結晶試料からの高効率回折データ収集装置を実用化
2016年5月18日
副生成物処理が不要なエステル化反応の触媒を開発
2016年5月17日
固体中の磁気モノポールが生み出す電磁気効果を観測
2016年5月10日
味覚受容の第1段階で起こる味覚受容体の構造変化を解明
2016年5月10日
メモリーB細胞の分化誘導メカニズムを解明
2016年5月10日
1兆分の1秒で起きる磁気的性質の変化を観察
2016年5月10日
遺伝子発現から転写因子を予測

2016年4月29日
神経突起を光で誘導
2016年4月28日
ミトコンドリアゲノムの初期化機構を発見
2016年4月27日
乱雑さを決める時間の対称性を発見
2016年4月27日
ヘミメチルDNAの新機能
2016年4月26日
将来の疲労の程度を予測する脳のメカニズムを発見
2016年4月26日
アトピー性皮膚炎モデルの原因遺伝子を解明
2016年4月26日
シナプス強度の調節機構を発見
2016年4月25日
グラフェンの先へ 新材料でトランジスタを開発
2016年4月22日
世界初!ビームサイズを自由自在に制御できるX線ナノビームの形成に成功
2016年4月21日
細胞周期を止めても「時計」は進む
2016年4月21日
細胞をドーナツ型に変形させる力の源
2016年4月18日
結晶を損傷しない新しいタンパク質結晶の輸送媒体を発見
2016年4月13日
生命の設計図DNAは、不規則に折り畳まれる性質をもつ!
2016年4月13日
リチウムホウ素化合物の新しい合成法を開発

2016年4月12日
骨硬化性骨幹端異形成症の原因遺伝子を発見
2016年4月12日
カラム分離なしで複雑な代謝混合物を構造解析
2016年4月12日
アクロレインの可視化に成功
2016年4月12日
肝臓がん300例の全ゲノムを解読
2016年4月8日
精子が卵子を活性化する新しい仕組みを解明
2016年4月7日
生きた生物の神経細胞が伸長する方向を光で誘導する
2016年4月7日
走化性細胞が応答範囲を拡張するメカニズム
2016年4月2日
マウスiPS細胞から皮膚器官系の再生に成功
2016年4月1日
動物の争いでいつ降参するかを決める神経回路
2016年3月25日
SACLAでの構造解析に必要な結晶の量を数百分の1に
2016年3月23日
世界最大のヒト遺伝子クローンライブラリーを構築
2016年3月23日
折れ曲がった形の糖鎖を可視化
2016年3月23日
太陽風が引き起こす木星の強力なオーロラ
2016年3月22日
微弱な電気刺激が脳を活性化する仕組みを解明
2016年3月19日
ディラック電子系に潜む普遍性を実証
2016年3月18日
なぜ私たちは眠るか
2016年3月18日
世界初、ポジトロニウム負イオンの共鳴状態の観測に成功
2016年3月18日
ES細胞の老化回避機構を解明
2016年3月17日
アルツハイマー病で記憶は失われていない可能性
2016年3月16日
スーパーコンピュータでフラーレンの性質を探る
2016年3月15日
有機ケイ素化合物の新しい合成法を開発
2016年3月15日
不安定な共役イミンが起こす多様な環化反応を発見
2016年3月15日
原子核からほんの少しあふれた2個の中性子
2016年3月15日
軸性脊椎骨幹端異形成症の原因遺伝子を発見
2016年3月11日
シナプスの微細構造まで鮮明に
2016年3月9日
神経因性の先天性多発性関節拘縮症の原因の解明
2016年3月9日
分子混雑が計測できる蛍光タンパク質「GimRET」の開発
2016年3月8日
「小さくなると、閉じたゲートが開閉する」多孔性材料
2016年3月7日
髄膜炎菌感染症の新たな薬剤標的を発見
2016年3月1日
生命現象を支える化学反応の真の姿を解明!
2016年3月1日
酵母・カビの設計図の概要が多数明らかに
2016年3月1日
異なる原子の光格子時計を短時間で比較することに成功
2016年2月29日
地球内核の組成制約に成功
2016年2月26日
認知症モデルマウスの神経炎症を可視化
2016年2月26日
酵母のアミノ酸取り込みを調節する化合物を発見
2016年2月24日
質量のないディラック電子の磁気モーメントを精密測定
2016年2月23日
生体内部を高度に認識できる糖鎖複合体
2016年2月23日
白質消失病の発症機構
2016年2月23日
スキルミオン生成に表れるトポロジーの融合
2016年2月19日
放射性廃棄物の処理問題解決への第一歩
2016年2月17日
SACLA マルチビームライン運転に成功
2016年2月17日
コヒーレントX線の高効率利用法を提案・実証
2016年2月16日
強誘電体中の新たな量子現象を発見
2016年2月16日
糖鎖の新しい代謝機構を解明
2016年2月16日
脳の進化的起源を解明
2016年2月13日
原子の瞬間移動のサブ・ナノメートルの分解能での実時間観測に成功
2016年2月11日
リアルタイムPCRを手軽にデザイン
2016年2月10日
クロザピンがもつ副作用のリスク遺伝子を同定
2016年2月5日
表面反応素過程での新しいエネルギー伝搬
2016年2月4日
イネの高温ストレス耐性を向上する方法の開発
2016年2月4日
シルク材料での水の影響を解明
2016年2月2日
銅酸化物の超伝導はなぜ高温か?
2016年2月1日
質量ゼロのディラック電子の流れを制御できる新しい磁石を発見
2016年2月1日
XFELの光特性を非破壊で評価する手法を開発
2016年2月1日
薬剤分子の新たな化学変換法
2016年1月29日
思春期特発性側弯症(AIS)の原因遺伝子LBX1が側弯を引き起こす仕組みを解明
2016年1月29日
XFELと顕微鏡の相補利用で生体試料を高効率に観察
2016年1月29日
鉄系超伝導体のフォノンと磁性
2016年1月28日
ペプチド凝集の物理化学的起源を計算機シミュレーションにより解明
2016年1月28日
2型糖尿病に関わる新たな遺伝子領域を発見
2016年1月25日
フェムト秒で起こるX線損傷過程の観測に成功
2016年1月22日
トポロジカル絶縁体による4π周期の超伝導状態を世界で初めて観測
2016年1月21日
トゥレット障害の発症メカニズム解明に新展開
2016年1月21日
虚血性心疾患の新たな遺伝的要因を発見
2016年1月21日
川崎病の発症に関わる「ORAI1遺伝子の多型」を発見
2016年1月20日
細胞内シグナルのアナログ・デジタル変換
2016年1月19日
四肢形成における分子メカニズムの一端を解明
2016年1月19日
上皮細胞の微小管配向の謎を解明
2016年1月18日
先天性外眼筋繊維症に伴う神経発達異常の仕組みを解明
2016年1月18日
エイズウイルスの細胞間感染の新たなメカニズムを解明
2016年1月15日
ヒトES細胞から機能的な下垂体ホルモン産生細胞の分化に世界で初めて成功
2016年1月12日
キラーT細胞に重要な樹状細胞の生体内可視化に成功
2016年1月11日
レーザーでトンネルコンクリートの健全性を高速で検査する
2016年1月8日
植物Y染色体遺伝子地図を作成
2016年1月8日
陽子内部のグルーオンの向きを精密測定
2016年1月8日
肝がん再発予防薬の作用メカニズムを解明
2016年1月8日
コンパクト超高磁場NMRの実現へ
2016年1月8日
次世代型逆遺伝学による睡眠遺伝子Nr3aの発見


2016年1月5日
植物の高温に対する初期応答のメカニズムを解明
